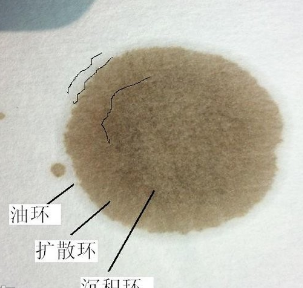

中速滤纸孔径为30~50微米。

定性滤纸的孔径是不规表州刻棉固律的,通常定性滤纸的孔隙大,定量的小。滤纸滤过速度的不同,孔径也不同。一般定性滤纸孔径大而且也没有很货器族续严格的规定。定量滤纸分为快速、中速和慢速三种,其孔径分别大约是80~120微米、30~50微米、和1~3微米。
按照孔隙的大小,滤纸可分为快来自速,中速和慢速3种。快速滤纸孔隙最大,慢速滤纸孔隙最小。

快速滤纸,因纸质疏松,斑点易扩散,适合于Rf值较大的样品和粘度较大的展开剂。
慢速滤纸,斑点不易扩散,适合于Rf值较小的样品和粘度较小动料的展开剂,但展开时封抓孩各医失以深间较长。
中速滤纸界于两者之间。
颜色区别:
1、定量滤纸
快速:黑色或白色纸带
中速:蓝色纸带
慢速:红色或橙色重纸带
2、定性滤纸:
快速:黑色或白色纸带
中速:蓝色纸带
慢速:红色或橙色纸带
免责声明
本文仅代表作者观点,不代表本站立场,著作权归作者所有;作者投稿可能会经本站编辑修改或补充;本网站为服务于中国中小企业的公益性网站,部分文章来源于网络,百业信息网发布此文仅为传递信息,不代表百业信息网赞同其观点,不对内容真实性负责,仅供用户参考之用,不构成任何投资、使用建议。请读者自行核实真实性,以及可能存在的风险,任何后果均由读者自行承担。如广大用户朋友,发现稿件存在不实报道,欢迎读者反馈、纠正、举报问题;如有侵权,请反馈联系删除。(反馈入口)
本文链接:https://www.byxxw.com/zixun/33126.html










